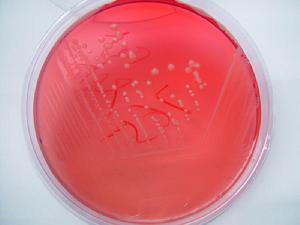
土黴素

概述
 土黴素片
土黴素片功能作用
 注射用土黴素
注射用土黴素本品對淋球菌和腦膜炎球菌具一定抗菌活性,但耐青黴素的淋球菌對土黴素也耐藥。多年來由於四環素類的廣泛套用,臨床常見病原菌對土黴素耐藥現象嚴重,包括葡萄球菌等革蘭陽性菌及多數革蘭陰性桿菌。四環素類抗生素的不同品種之間存在交叉耐藥。
本品作用機制為藥物能特異性地與細菌核糖體30S亞基的A位置結合,抑制肽鏈的增長和影響細菌蛋白質的合成。
用於痢疾、沙眼、結膜炎、肺炎、中耳炎、皮膚化膿感染等。亦用於治療阿米巴腸炎及腸道感染。
適應症
培養皿中的不動桿菌
培養皿中的不動桿菌(1)立克次體病,包括流行性斑疹傷寒、地方性斑疹傷寒、洛磯山熱、恙蟲病和Q熱。
(2)支原體屬感染。
(3)衣原體屬感染,包括鸚鵡熱、性病、淋巴肉牙腫、非特異性尿道炎、輸卵管炎、宮頸炎及沙眼。
(4)回歸熱。
(5)布魯菌病。
(6)霍亂。
(7)兔熱病。
(8)鼠疫。
(9)軟下疳。
治療布魯菌病和鼠疫時需與氨基糖苷類聯合套用。
3、本品可用於對青黴素類過敏的破傷風、氣性壞疽、雅司、梅毒、淋病和鉤端螺鏇體病以及放線菌屬、李斯特菌感染的患者。
4、可用於急性腸道阿米巴病和中、重度痤瘡患者作為輔助治療。
用法用量
口服
成人0.25g~0.5g/次,3~4次/日。兒童(8歲以上)每日30mg~40mg/kg,3~4次/日。
藥物過量
本品無特異性拮抗藥,藥物過量時應給予催吐、洗胃及大量飲水及補液等對症治療及支持治療。
注意事項
孕婦、哺乳期婦女及小兒禁用。參閱鹽酸四環素。
有四環素類藥物過敏史者禁用。
1、交叉過敏反應:對一種四環素類藥物呈現過敏者可對本品呈現過敏。
2、對診斷的干擾:
(1)測定尿鄰苯二酚胺(Hingerty法)濃度時,由於本品對螢光的干擾,可使測定結果偏高。
(2)本品可使鹼性磷酸酶、血尿素氮、血清澱粉酶、血清膽紅素、血清氨基轉移酶(AST、ALT)的測定值升高。
3、長期用藥應定期檢查血常規以及肝、腎功能。
4、口服本品時,應飲用足量(約240ml)水,避免食道潰瘍和減少胃腸道刺激症狀。
5、本品宜空腹口服,即餐前1小時或餐後2小時服用,避免食物對吸收的影響。
6、下列情況存在時須慎用或避免套用:
(1)由於本品可致肝損害,因此原有肝病者不宜用此類藥物。
(2)由於本品可加重氮質血症,已有腎功能損害不宜套用此類藥物,如確有指征套用時須慎重考慮,並調整劑量。
7、治療性病時,如懷疑同時合併梅毒螺鏇體感染,用藥前須行暗視野顯微鏡檢查及血清學檢查,後者每月1次,至少4次。
妊娠期用藥
本品可透過胎盤屏障進入胎兒體內,沉積在牙齒和骨的鈣質區內,引起胎兒牙齒變色、牙釉質再生不良及抑制胎兒骨骼生長,該類藥物在動物中有致畸胎作用,因此妊娠期婦女不宜使用本品。
本品可自乳汁分泌,乳汁中濃度較高,對乳兒有潛在的發生嚴重不良反應的可能,乳母套用時應停止授乳。
兒童用藥
本品可在任何骨組織中形成穩定的鈣化合物,導致恆齒黃染、牙釉質發育不良和骨生長抑制,故8歲以下小兒禁用本品。
老年患者用藥
老年患者常伴有腎功能減退,套用本品,易引起肝毒性,故老年患者需慎用。
製劑規格
1.片劑:0.125g、0.25g。2.膠囊:0.25g。
3.軟膏:3000萬U。
4.眼膏:300萬U。
動物藥用
性狀
 土黴素
土黴素藥理作用
本品具有廣譜抗菌作用,對敏感菌包括肺炎球菌、鏈球菌、部分葡萄菌、炭疽桿菌、破傷風桿菌、對豬肺炎支原體、衣原體、螺鏇體,也有一定的抑制作用。功能主治
1、對豬的副傷寒、附紅細胞體、炭疽病、喘氣病、痢疾、豬肺疫、療效顯著。2、雛禽痢疾、衣原體病、還可以用緩解應激反應、提高產蛋量、促進幼禽增重等。
3、水產套用於治療魚類弧病菌、脫磷病、爛鰓病、鰻魚受德化氏病、鱒魚瘡病、鰻赤鰭病等。
用法用量
混飲;每袋100g兌水400kg,連用3-5天混飼:每袋100g拌料200kg,連用3-5天
中毒症狀
土黴素進入機體後,吸收快,排泄慢(達12小時以上),因此,不論一次大劑量或連續超劑量用藥均能引起中毒。能使腸道菌群失調,引起黴菌與其他細菌繼發感染,使機體發生二重感染,即清除或抑制敏感細菌,但不敏感的或具有耐藥性的細菌則能大量繁殖而侵人,從而產生危害。還能使肝發生脂肪變性,對肝酶系統產生不利影響,並改變機體中的凝血因子,導致凝血障礙,對消化道黏膜刺激性較強,在酸性環境中對局部刺激性最強。注射幾分鐘後即表現狂躁不安,全身痙攣,肌肉震顫,以後四肢站立如木馬狀,張口呼吸,呈腹式呼吸,口吐大量泡沫,結膜潮紅,瞳孔散大,反射消失,呼吸、心跳次數增多(心跳120—140次/分)。
口服中毒時,嘔吐、腹瀉、黃疽。有的發生昏睡,全身肌肉鬆弛,伏臥不安,耳尖發冷,心跳增快。

